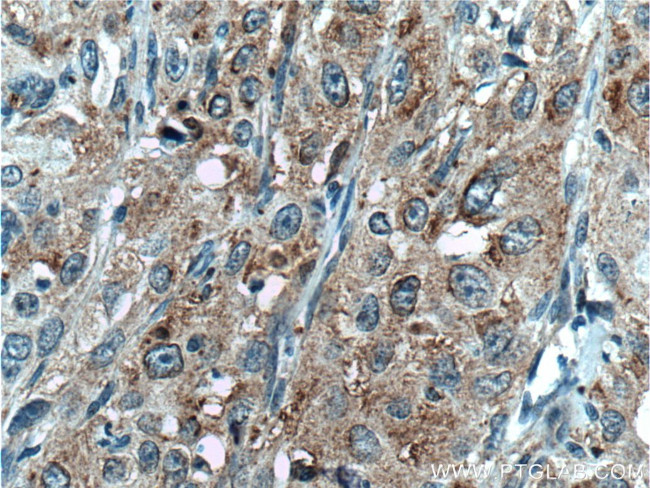
SAT2 Antibody in Immunohistochemistry (Paraffin) (IHC (P))

Search
Proteintech
SAT2 Polyclonal Antibody
{{$productOrderCtrl.translations['antibody.pdp.commerceCard.promotion.promotions']}}
{{$productOrderCtrl.translations['antibody.pdp.commerceCard.promotion.viewpromo']}}
{{$productOrderCtrl.translations['antibody.pdp.commerceCard.promotion.promocode']}}: {{promo.promoCode}} {{promo.promoTitle}} {{promo.promoDescription}}. {{$productOrderCtrl.translations['antibody.pdp.commerceCard.promotion.learnmore']}}
产品信息
16246-1-AP
种属反应
已发表种属
宿主/亚型
分类
类型
抗原
偶联物
形式
浓度
规格
纯化类型
保存液
内含物
保存条件
运输条件
产品详细信息
Immunogen sequence: MASVRIREA KEGDCGDILR LIRELAEFEK LSDQVKISEE ALRADGFGDN PFYHCLVAEI LPAPGKLLGP CVVGYGIYYF IYSTWKGRTI YLEDIYVMPE YRGQGIGSKI IKKVAEVALD KGCSQFRLAV LDWNQRAMDL YKALGAQDLT EAEGWHFFCF QGEATRKLAG K (1-170 aa encoded by BC011751)
靶标信息
SAT2 is an enzyme which catalyzes the acetylation of polyamines. Substrate specificity: norspermidine > spermidine = spermine >> N(1)acetylspermine = putrescine.
仅用于科研。不用于诊断过程。未经明确授权不得转售。
生物信息学
蛋白别名: Diamine acetyltransferase 2; diamine N-acetyltransferase 2; polyamine N-acetyltransferase 2; Spermidine/spermine N(1)-acetyltransferase 2; spermidine/spermine N1-acetyl transferase 2; SSAT-2; Thialysine N-epsilon-acetyltransferase
基因别名: 2610016A03Rik; SAT2; SSAT-2; SSAT2
UniProt ID: (Human) Q96F10, (Mouse) Q6P8J2
Entrez Gene ID: (Human) 112483, (Rat) 360547, (Mouse) 69215